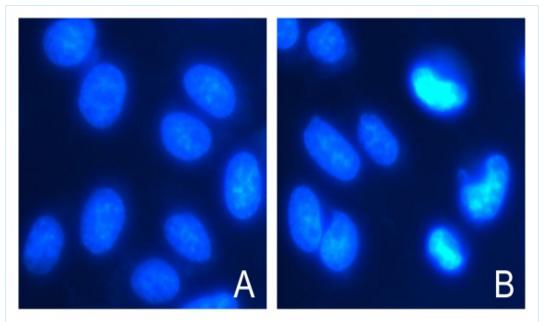

Hochest 33342即用型染色液
Hochest 33342 Stain
RTU Solution,10 μg/ml
● 產品組成:
|
貨號
|
名稱
|
規格
|
貯存
|
|
HE1013S
|
Hochest
33342即用型染色液
|
10
ml
|
-20℃
|
|
|
說明書
|
一份
|
|
● 產品簡介:
Hoechst 33342,也稱bisBenzimide
H 33342 或HOE 33342,分子式為C27H28N6O·3HCl
,分子量MW561.93,CAS:
23491-52-3,是一種可以穿透細胞膜的藍色熒光染料,對細胞的毒性較低。Hoechst
33342 專一性地與雙鏈DNA結合(優先結合AT),常用于細胞核染色。染色后可以用熒光顯微鏡觀察或流式細胞儀檢測。Hoechst 33342 的最大激發波長為346 nm(紫外激發),最大發射波長為460nm(藍色熒光);Hoechst 33342 和雙鏈DNA 結合后,最大激發波長為350nm,最大發射波長為461nm。另外,由于Hoechst 33342專一性結合DNA,不與RNA結合,樣品無需使用RNase處理。與DAPI相比,Hoechst
33342具有更好的膜通透性,更適合于活細胞的染色。
Hoechst 33342和Hoechst
33258相比,Hoechst 33342對細胞的毒性作用更小一些,33258穿透能力較33342弱,染活細胞時容易被"泵出",也就是拒染。所以一般來說Hoechst 33258用于細胞固定后再染色,而Hoechst33342則可以對活細胞直接進行染色。
本染色液為即用型,濃度為10
μg/ml,可直接用于固定細胞或組織的細胞核染色,也可直接用于活細胞或組織的細胞核染色。
● 貯存:
-20℃避光保存,一年有效。
● 操作步驟:
一.固定后的細胞樣品染色:
1.1 貼壁細胞:
1.1.1 取潔凈蓋玻片在70%乙醇中浸泡5分鐘或更長時間,無菌超凈臺內吹干或用無菌的PBS洗滌三遍,再用細胞培養液洗滌一遍。將蓋玻片置于六孔板內,種入細胞培養過夜,生長至50%-80%滿度。
1.1.2刺激細胞發生凋亡后,吸盡培養液,加入0.5
ml固定液,固定10分鐘或更長時間(可4℃過夜)。
1.1.3去盡固定液,用PBS洗兩遍,每次3分鐘,吸盡液體。洗滌時宜用搖床或手動晃動。
1.1.4加入0.5
ml Hoechst 33342染色液,37℃避光染色10-15分鐘,手動晃動數次。
1.1.5去盡染色液,用PBS洗兩遍,每次3分鐘,吸盡液體。洗滌時宜用搖床或手動晃動。
1.1.6滴一滴抗熒光淬滅封片液于載玻片上,蓋上貼有細胞的蓋玻片,讓細胞接觸封片液,盡量避免氣泡。
1.1.7 熒光顯微鏡使用紫外激發,可檢測到呈藍色的細胞核。激發波長350nm左右,發射波長460nm左右。
注:熒光染料都存在淬滅的問題,建議染色后盡快檢測。
1.2懸浮細胞:
1.2.1 500 g(2400
rpm,下同)離心收集凋亡處理后細胞樣品于1.5 ml離心管內,加入0.5
ml固定液,緩緩懸起細胞,常溫固定10分鐘或更長時間(可4℃過夜)。
1.2.2離心去盡固定液,用PBS洗兩遍,每次3分鐘,洗滌期間手動晃動數次。
1.2.3 細胞沉淀中加入0.5
ml Hoechst 33342染色液,37℃避光染色10-15分鐘,手動晃動數次。
1.2.4 離心收集沉淀,重懸于100 μl PBS中。
1.2.5 取5 μl抗熒光淬滅封片液于載玻片上,加入等體積步驟1.2.4染色后細胞重懸液,蓋上一潔凈的蓋玻片,盡量避免氣泡。
1.2.6 熒光顯微鏡下紫外激發,可檢測到呈藍色的細胞核。激發波長350 nm左右,發射波長460 nm左右。
注:熒光染料都存在淬滅的問題,建議染色后盡快檢測。
二.活細胞染色:
2.1 加入適當量Hoechst 33342染色液,必須充分覆蓋住待染色的樣品,通常對于六孔板一個孔需加入1 ml染色液,對于96孔板一個孔需加入100微升染色液。
2.2 在適宜于細胞培養的溫度下培養20-30分鐘。棄染色液,用PBS洗滌2-3次即可進行熒光檢測。細胞發生凋亡時,在熒光顯微鏡下觀察會看到凋亡細胞的細胞核呈致密濃染,或呈碎塊狀致密濃染。
三. 實驗示例:
HeLa細胞染色圖。圖A為正常細胞Hoehst
33342的染色效果圖。圖B中除了正常細胞外,還清晰可見呈現致密濃染的凋亡細胞。

操作流程: Jurkat細胞,計數1×106/ml;500 g 3 min收集2 ml 細胞;細胞沉淀中加入1 ml卡諾固定液,常溫固定10 min;1×PBS漂洗兩次;細胞沉淀中加入200 μl Hoechst 33342即用型染色液(10 μg/ml);37度避光染色10 min; 離心后細胞沉淀重懸于100 μl 1×PBS中;取5 μl細胞懸液滴于載玻片上,加5 μl 抗熒光淬滅劑,封片觀察。